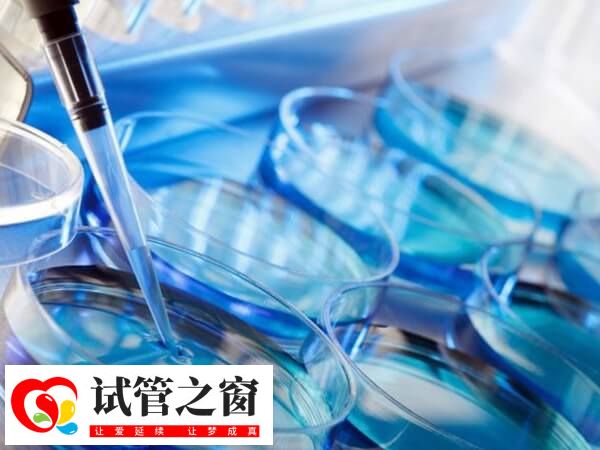
PGT檢測可篩查健康胚胎移植

哪些人需要做第三代試管
一般來說,對于存在高齡、染色體異常、反復(fù)移植失敗、單基因遺傳病患者或攜帶者、具有遺傳易感性嚴(yán)重疾病的夫婦等來說,通常是比較適合進(jìn)行三代試管嬰兒移植的。這樣可以幫助降低遺傳病的傳播風(fēng)險,提高臨床妊娠率,降低流產(chǎn)率,幫助不孕不育的夫婦實現(xiàn)生育愿望。

三代試管嬰兒適應(yīng)人群
第三代試管嬰兒,即胚胎植入前遺傳學(xué)診斷技術(shù)(PGD),適用于以下幾類人群:
1、胚胎移植反復(fù)失敗
在體外受精和胚胎移植期間,在最近的胚胎移植中連續(xù)兩次或兩次以上未建立臨床妊娠的人。
2、習(xí)慣性反復(fù)流產(chǎn)
在過去懷孕期間重復(fù)兩次或兩次以上的臨床流產(chǎn),并在流產(chǎn)期間獲得臨床信息。
3、染色體結(jié)構(gòu)異常
對夫妻中任何一方有影響重生產(chǎn)染色體結(jié)構(gòu)異常的人。
第三代試管嬰兒PGT檢測
第三代試管嬰兒胚胎移植前遺傳學(xué)測試(PGT:preimplantation genetic testing)是一種新型的輔助生殖醫(yī)學(xué),從受精后的胚胎中取出5到10個細(xì)胞,檢查染色體和基因。如果大家想要了解,三代試管PGT類型有哪些,如下所致:
- 1 、PGT-A:PGT 檢查由于染色體數(shù)量異常而增加或減少的每個染色體;
- 2、 PGT-SR:檢查染色體結(jié)構(gòu)異常引起的染色體部分過剩或缺失的PGT;
- 3、 PGT-M:PGT 研究可能導(dǎo)致嚴(yán)重遺傳性疾病的基因突變。
這些措施能夠幫助降低遺傳病的傳播風(fēng)險,提高臨床妊娠率,降低流產(chǎn)率,幫助不孕不育的夫婦實現(xiàn)生育愿望。
第三代試管嬰兒PGT檢測流程
胚胎植入前遺傳學(xué)診斷技術(shù)(PGT)也就是我們常說的第三代試管嬰兒。作為一級預(yù)防手段通過直接挑選遺傳物質(zhì)正常的胚胎進(jìn)行移植,可以有效減少出生缺陷的發(fā)生。如果大家想要了解,第三代試管嬰兒PGT檢測流程,如下所示:
1、通過刺激超排卵來回收卵子進(jìn)行體外受精;
2、確認(rèn)并培養(yǎng)回收的卵子的體外受精(或顯微授精);
3、獲得胚泡后,活檢幾個細(xì)胞。在這項研究中,從采卵第5天的胚泡期的營養(yǎng)外胚層(將來成為胎盤的部分)中,在顯微鏡下抓住胚泡,在透明帶上打孔,對其中的幾個細(xì)胞進(jìn)行活檢;
4、從囊胚中提取的細(xì)胞(活檢細(xì)胞)被運(yùn)送到PGT-A分析設(shè)施;
5、活檢后,胚泡一旦凍結(jié),就可以通過活檢細(xì)胞的染色體分析,確定染色體數(shù)量是否正常。實驗室從這個細(xì)胞中生長DNA,以適當(dāng)?shù)姆绞綑z查染色體數(shù)量的異常;
7、然后確定為可移植胚胎的胚泡融化并移植到子宮內(nèi),如果懷孕成功,請仔細(xì)檢查,直到懷孕12周左右。





